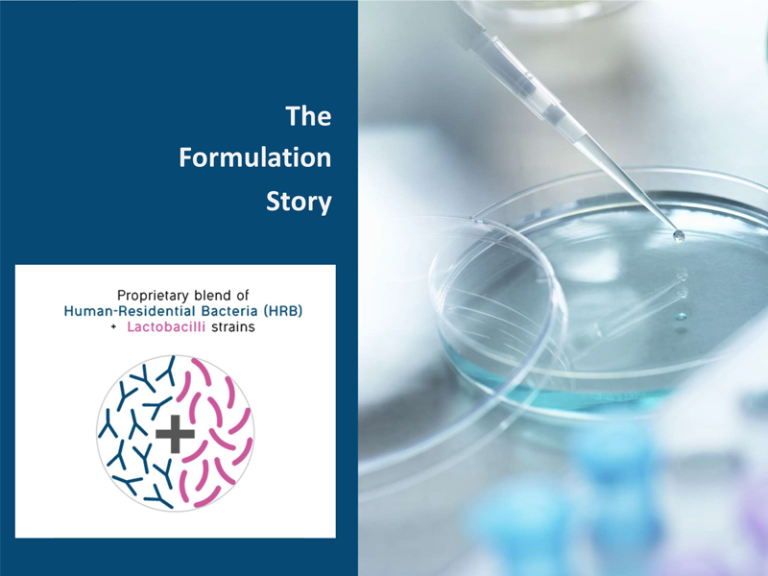

Key Considerations
Formulation Starts With Consumer
Every product we formulate starts with the consumer in mind. Beyond delivering functional benefits, we create solutions with a compelling story, ensuring they resonate emotionally. Consumers seek more than effectiveness—they want natural, trust, confidence, and meaningful experiences. By blending science with storytelling, we craft products that connect, inspire, and build lasting relationships. It’s about impact, engagement, and making every formula truly matter.

Understanding Mode of Action
Understanding the mode of action of sustainable active ingredients empowers consumers to make informed choices about the products they use. It ensures efficacy, safety, and transparency, helping buyers identify solutions that align with their values and long-term skin or health goals. By knowing how ingredients like Bateriophages work at a biological level, consumers can avoid misinformation, support eco-conscious innovation, and choose science-backed formulations that truly deliver results.
Understanding Supply Chain
Understanding the supply chain of sustainable active ingredients like Astaxanthin from microalgae empowers both brands and consumers to make eco-conscious choices in clean beauty. With 81% of consumers seeking clean labels and 49% prioritizing environmentally friendly skincare, transparency in sourcing and production is essential. By ensuring responsible ingredient extraction, ethical formulation, and sustainable practices, brands can build trust, enhance product efficacy, and align with the growing demand for science-backed, planet-friendly solutions.


